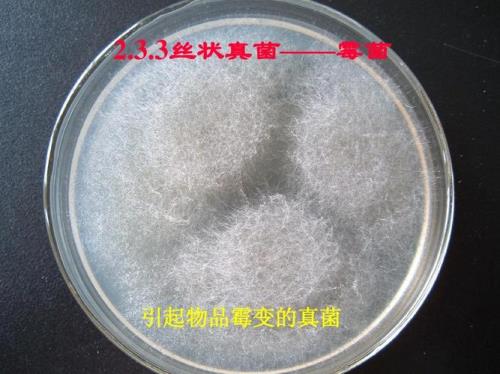

iphone备忘录设置面容解锁方法如下:
1、
打开要锁定的备忘录,点按“操作”按钮 或右上角的“…”按钮,然后轻点“锁定备忘录”。
2、
输入密码,然后务必为自己设置密码提示。此时您可以选择通过面容 ID 来访问锁定备忘录,轻点“完成”进行保存。

原创 | 2023-03-01 14:02:42 |浏览:1.6万
iphone备忘录设置面容解锁方法如下:
1、
打开要锁定的备忘录,点按“操作”按钮 或右上角的“…”按钮,然后轻点“锁定备忘录”。
2、
输入密码,然后务必为自己设置密码提示。此时您可以选择通过面容 ID 来访问锁定备忘录,轻点“完成”进行保存。

Copyright 2005-2020 www.kxting.com 版权所有 |  湘ICP备2023022655号
湘ICP备2023022655号
声明: 本站所有内容均只可用于学习参考,信息与图片素材来源于互联网,如内容侵权与违规,请与本站联系,将在三个工作日内处理,联系邮箱:47085,1089@qq.com